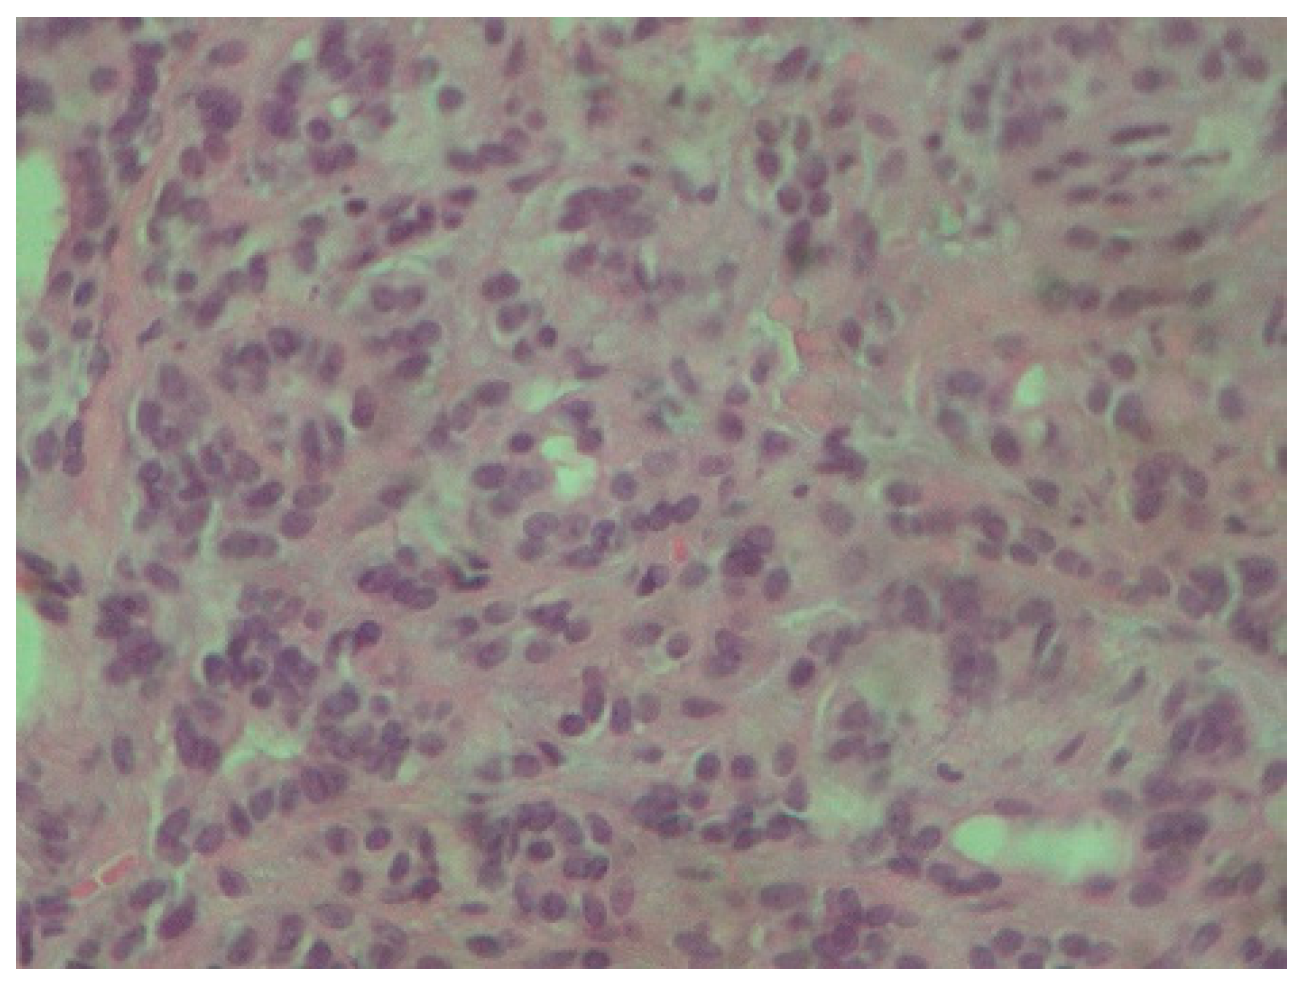
Reports 08 00070 g003 Reports 08 00070 g003

Exploring Oral Polymorphous Adenocarcinoma: Clinical Characteristics, Diagnosis, and Treatment Outcomes. A Case Report
Abstract
1. Introduction and Clinical Significance
2. Case Presentation
3. Discussion
4. Conclusions
Author Contributions
Funding
Institutional Review Board Statement
Informed Consent Statement
Data Availability Statement
Conflicts of Interest
References
- Colmenero, C.M.; Patron, M.; Burgueño, M.; Sierra, I. Polymorphous low-grade adenocarcinoma of the oral cavity: A report of 14 cases. J. Oral Maxillofac. Surg. 1992, 50, 595–600. [Google Scholar] [CrossRef] [PubMed]
- Chatura, K. Polymorphous low grade adenocarcinoma. J. Oral Maxillofac. Pathol. 2015, 19, 77–82. [Google Scholar] [CrossRef] [PubMed]
- Rooper, L.; Sharma, R.; Bishop, J.A. Polymorphous Low Grade Adenocarcinoma has a Consistent p63+/p40− Immunophenotype that Helps Distinguish it from Adenoid Cystic Carcinoma and Cellular Pleomorphic Adenoma. Head Neck Pathol. 2015, 9, 79–84. [Google Scholar] [CrossRef] [PubMed]
- De Araujo, V.C.; Passador-Santos, F.; Turssi, C.; Soares, A.B.; de Araujo, N.S. Polymorphous low-grade adenocarcinoma: An analysis of epidemiological studies and hints for pathologists. Diagn. Pathol. 2013, 8, 6. [Google Scholar] [CrossRef] [PubMed]
- Pires, F.R.; Perez, D.E.D.C.; De Almeida, O.P.; Kowalski, L.P. Estrogen receptor expression in salivary gland mucoepidermoid carcinoma and adenoid cystic carcinoma. Pathol. Oncol. Res. 2004, 10, 166–168. [Google Scholar] [CrossRef] [PubMed]
- Ito, F.A.; Ito, K.; Della Coletta, R.; Vargas, P.A.; Lopes, M.A. Immunohistochemical study of androgen, estrogen and progesterone receptors in salivary gland tumors. Braz. Oral Res. 2009, 23, 393–398. [Google Scholar] [CrossRef] [PubMed]
- Can, N.T.; Lingen, M.W.; Mashek, H.; McElherne, J.; Briese, R.; Fitzpatrick, C.; van Zante, A.; Cipriani, N.A. Expression of Hormone Receptors and HER-2 in Benign and Malignant Salivary Gland Tumors. Head Neck Pathol. 2017, 12, 95–104. [Google Scholar] [CrossRef] [PubMed]
- Miller, A.S.; Hartman, G.G.; Chen, S.Y.; Edmonds, P.R.; Brightman, S.A.; Harwick, R.D. Estrogen receptor assay in polymorphous low-grade adenocarcinoma and adenoid cystic carcinoma of salivary gland origin. An immunohistochemical study. Oral Surg. Oral Med. Oral Pathol. 1994, 77, 36–40. [Google Scholar] [CrossRef] [PubMed]
- Atiq, A.; Mushtaq, S.; Hassan, U.; Loya, A.; Hussain, M.; Akhter, N. Utility of p63 and p40 in Distinguishing Polymorphous Adenocarcinoma and Adenoid Cystic Carcinoma. Asian Pac. J. Cancer Prev. 2019, 20, 2917–2921. [Google Scholar] [CrossRef] [PubMed]
- Mimica, X.; McGill, M.; Hay, A.; Zanoni, D.K.; Shah, J.P.; Wong, R.J.; Ho, A.; Cohen, M.A.; Patel, S.G.; Ganly, I. Distant metastasis of salivary gland cancer: Incidence, management, and outcomes. Cancer. 2020, 126, 2153–2162. [Google Scholar] [CrossRef] [PubMed]
- Fife, T.A.; Smith, B.; Sullivan, C.A.; Browne, J.D.; Waltonen, J.D. Polymorphous low-grade adenocarcinoma: A 17 patient case series. Am. J. Otolaryngol. 2013, 34, 445–448. [Google Scholar] [CrossRef] [PubMed]
- Paleri, V.; Robinson, M.; Bradley, P. Polymorphous low-grade adenocarcinoma of the head and neck. Curr. Opin. Otolaryngol Head Neck Surg. 2008, 16, 163–169. [Google Scholar] [CrossRef] [PubMed]
- Haddad, R.; Colevas, A.D.; Krane, J.F.; Cooper, D.; Glisson, B.; Amrein, P.C.; Weeks, L.; Costello, R.; Posner, M. Herceptin in patients with advanced or metastatic salivary gland carcinomas. A phase II study. Oral Oncol. 2003, 39, 724–727. [Google Scholar] [CrossRef] [PubMed]
- de Aquino, S.N.; de Cáceres, C.V.B.L.; Bezerra, H.K.F.; de Paiva, J.P.G.; Louredo, B.V.R.; Santos-Silva, A.R.; Lopes, M.A.; Vargas, P.A. Clinicopathological Features of 26 Intraoral Polymorphous Adenocarcinomas from a Single Brazilian Institution. Head Neck Pathol. 2024, 18, 63. [Google Scholar] [CrossRef] [PubMed]
- Goldfarb, M.; Brower, S.; Schwaitzberg, S.D. Minimally invasive surgery and cancer: Controversies part 1. Surg. Endosc. 2010, 24, 304–334. [Google Scholar] [CrossRef] [PubMed][Green Version]
- Valletti, P.A.; Campagnoli, M.; Dell'Era, V.; Garzaro, M.; Boffano, P.; Neirotti, F.; AM, M.; Brucoli, M. Oral and oropharyngeal malignant minor salivary gland tumors: A retrospective study. J. Stomatol. Oral Maxillofac. Surg. 2024, 125 (Suppl. S4), 101893. [Google Scholar] [CrossRef] [PubMed]

Disclaimer/Publisher’s Note: The statements, opinions and data contained in all publications are solely those of the individual author(s) and contributor(s) and not of MDPI and/or the editor(s). MDPI and/or the editor(s) disclaim responsibility for any injury to people or property resulting from any ideas, methods, instructions or products referred to in the content. |
© 2025 by the authors. Licensee MDPI, Basel, Switzerland. This article is an open access article distributed under the terms and conditions of the Creative Commons Attribution (CC BY) license (https://creativecommons.org/licenses/by/4.0/).
Share and Cite
Charisi, C.; Zisis, V.; Papadopoulos, P.; Poulopoulos, K.; Kyriakou, N.; Poulopoulos, A. Exploring Oral Polymorphous Adenocarcinoma: Clinical Characteristics, Diagnosis, and Treatment Outcomes. A Case Report. Reports 2025, 8, 70. https://doi.org/10.3390/reports8020070
Charisi C, Zisis V, Papadopoulos P, Poulopoulos K, Kyriakou N, Poulopoulos A. Exploring Oral Polymorphous Adenocarcinoma: Clinical Characteristics, Diagnosis, and Treatment Outcomes. A Case Report. Reports. 2025; 8(2):70. https://doi.org/10.3390/reports8020070
Chicago/Turabian StyleCharisi, Christina, Vasileios Zisis, Petros Papadopoulos, Konstantinos Poulopoulos, Nikolaos Kyriakou, and Athanasios Poulopoulos. 2025. "Exploring Oral Polymorphous Adenocarcinoma: Clinical Characteristics, Diagnosis, and Treatment Outcomes. A Case Report" Reports 8, no. 2: 70. https://doi.org/10.3390/reports8020070
APA StyleCharisi, C., Zisis, V., Papadopoulos, P., Poulopoulos, K., Kyriakou, N., & Poulopoulos, A. (2025). Exploring Oral Polymorphous Adenocarcinoma: Clinical Characteristics, Diagnosis, and Treatment Outcomes. A Case Report. Reports, 8(2), 70. https://doi.org/10.3390/reports8020070




